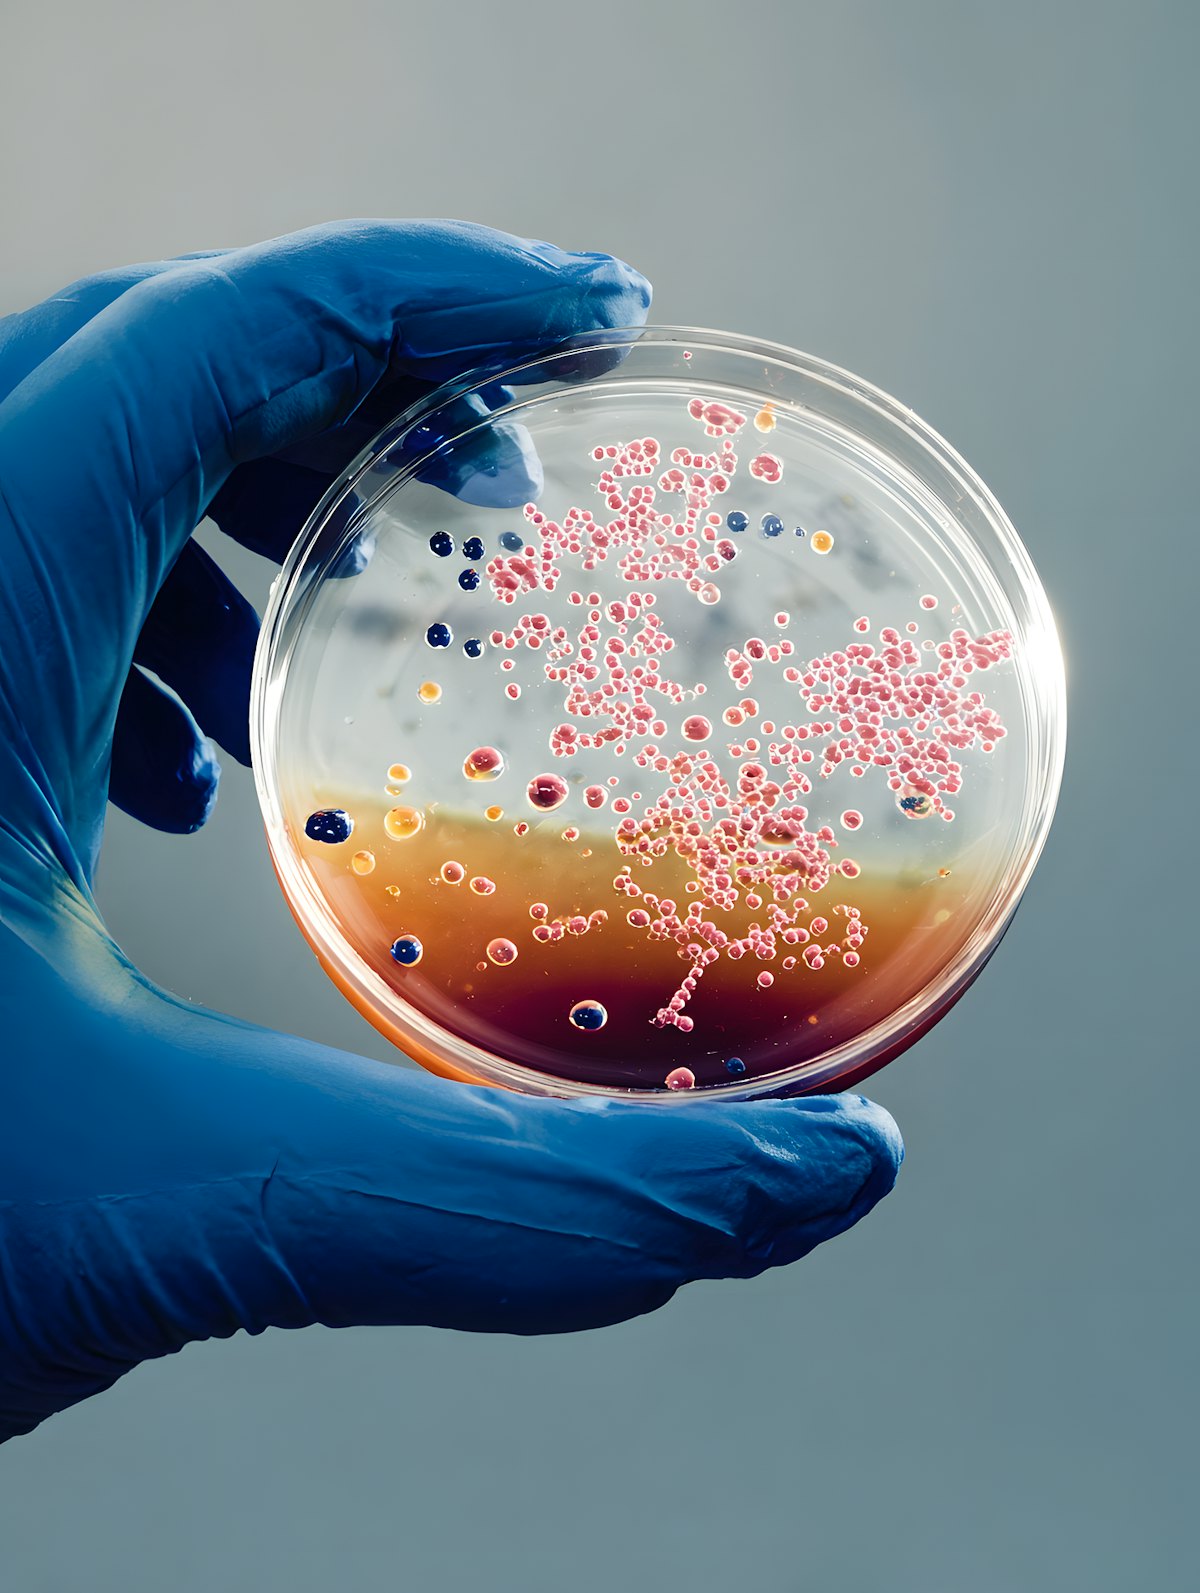

Read the latest news from regional and global sources, presenting different voices and perspectives.

Energy diplomacy: How India is playing its oil game
India's foreign policy has long been defined by strategic autonomy and multilateral engagement. This stance has become more visible amid growing global polarisations due to the Russia-Ukraine war. Recent developments surrounding Russian oil have...

Trump Blasts UN Shipping Emissions Plan, Forces Yearlong Delay
The International Maritime Organization has delayed a key vote to cut emissions from global shipping after U.S. President Donald Trump threatened sanctions on nations backing the proposal. The postponement on Friday stops the Net Zero Framework...

Consumers trust farmers but still want hard data to back environmental claims
Farmers deliver food to exemplary standards under tough regulation. Farmer led assurance schemes have a part to play in translating that unseen graft into consumer confidence. But when marketing runs ahead of measurement, we hand our critics an...

‘Disgraceful’: U.S. Lobbying Blocks Global Fee on Shipping Emissions
The Trump administration has succeeded in blocking a global fee on shipping emissions as an international maritime meeting adjourned Friday without adopting regulations. The world’s largest maritime nations had been deliberating on adopting...

No ‘Swap Deal’ on Fighter Jets or Missiles During Brazil-India Defence Talks: Brazilian Officials
Amid rising speculation around a potential ‘swap deal’ involving India’s Akash missile system and Brazil’s C-390 Millennium transport aircraft, senior Brazilian officials have firmly denied any such arrangement during high-level defence meetings...

Countries vote to delay implementation of carbon-free shipping plan
The 2023 IMO GHG (greenhouse gas) Strategy — the umbrella framework — envisages, in particular, a minimum 40% reduction in carbon intensity of international shipping (to reduce CO2 emissions per transport work) by 2030. File | Photo Credit: Getty...

Brazil Turns Fighter Deal Into Industry: Second Gripen Line Anchors a Latin American Aerospace Hub
Saab has opened a second rear-fuselage line for the F-39 Gripen in São Bernardo do Campo, just outside São Paulo, doubling capacity to as many as 16 shipsets a year. It is the clearest sign yet that Brazil’s decade-old fighter deal has shifted...
Brazil: patent developments in medtech, pharmaceuticals, telecom and AI
In summary Brazil has seen an increase in patent litigation. Sectors such as medtech, pharmaceuticals, telecom and AI have experienced more cases as the economy grows. Courts remain aligned that strong enforcement measures should be available...

UNâs global shipping carbon tax threatens U.S. economy — Trump officials mount last-ditch effort to block it
UN’s global shipping carbon tax threatens U.S. economy — Trump officials mount last-ditch effort to block it The UN’s International Maritime Organization (IMO) is set to impose a carbon tax on shipping fuel, ranging from 19 to 150 per ton of CO2...

Elevating Vietnamese agricultural products through biotechnology
HÀ NỘI — Biotechnology is considered a strategic sector, helping Vietnamese agricultural products gain economic advantages, improving exploitation efficiency and enhancing international competitiveness. Deputy Minister of Agriculture and...

Trump administration derails global carbon fee on shipping
(AP) — With trade threats from President Donald Trump, the U.S. derailed the world’s first global carbon fee on shipping as an international maritime meeting adjourned Friday without adopting regulations. Earlier this year, amid much fanfare, the...

US blocks global fee on shipping emissions as international meeting ends without new regulations
With trade threats from President Donald Trump, the U.S. derailed the world's first global carbon fee on shipping as an international maritime meeting adjourned Friday without adopting regulations. Earlier this year, amid much fanfare, the world's...

M&A Matures Brazil’s Bioinputs Market: Innovation Meets Global Strategy
The mergers and acquisitions (M&A) landscape in Brazil’s agribusiness has entered a new stage of maturity, with biological inputs now standing at the center of strategic transactions. Once dominated by rapid expansion and opportunistic growth, the...

India, Brazil will have “economic complementarity,” Brazil VP says
New Delhi [India], October 18 (ANI): Brazilian Vice President Geraldo Alckmin clarified that India and Brazil's cooperation is complimentary, and is not competitive. Alckmin responding to ANI's question on the positioning of India and Brazil as...
Brazil poultry sector launches prudent use antibiotic campaign
Every little bit helps – especially when multiplied, and where the fight against antibiotic resistance is concerned, the more that can be done the better. According to a World Health Organization report published earlier this month, one in six...

Shipping emissions levy shelved as countries bow to US pressure
Under intense pressure from Donald Trump’s government, countries have postponed plans to force shipowners to start paying for the damage they do to the climate. US officials were accused of “bullying” and “intimidation”, as nations met in London...
Roquette opens dedicated Health & Pharma Solutions Business Group’s Innovation Center in São Paulo, Brazil
Roquette, a global leader in plant-based ingredients and pharmaceutical excipients for health, nutrition and bio industrial markets, celebrates the grand opening of its dedicated Health & Pharma Solutions Business Group’s Innovation Center in São...

Brazil's exports to the U.S. fall 20.3% in September
The sharpest declines in shipments to the United States in September included coffee, Brazilian government figures show. Photo by Andre Borges/EPA Oct. 17 (UPI) -- Brazil's exports to the United States fell 20.3% in September compared with the...

Under shadow of Trump tariffs, India & Brazil to expand Mercosur pact. ‘Should be done in 10 months’
New Delhi: Brazil expects that the expansion of tariff lines in the India-Mercosur trade agreement will be completed within “ten months” said Brazilian Vice President Geraldo Alckmin Friday. Alckmin also highlighted Brazil’s keen interest in...

Trump torpedoes international deal to reduce shipping emissions
Members of the International Maritime Organization (IMO) have voted to postpone approving a plan to curb shipping emissions, after United States President Donald Trump threatened to impose sanctions on countries that supported the measure. The...